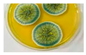
Catalysts 13 01446 i015

Abstract
In recent decades, several studies have been conducted on sustainability progress with high efficiency of renewable energies by utilizing advanced nano-module catalysts. Some collaborative studies advocate the unique characteristics of unconventional materials, including carbon nanotubes, nanosheets, nanoparticles, conducting polymers, integrated nano polymers, nano enzymes, and zero-dimensional nanomaterials/carbon dots (CDs) at the atomic and molecular level to generate efficient energy from various biomass substrates. Nanotechnology-based catalysts are considered a crucial tool for revolutionizing various energy-related applications. This review article addresses the sustainable and scarce biomass resources to synthesize CDs, properties, mechanisms, and insights with the advancement of research on CDs as nanocatalysts in the field of energy applications. These materials possess exceptional and rapidly expanding features such as being non-toxic, biocompatible, having excellent electrocatalytic activity and photoluminescence, and being highly dispersible in water. Because of these advantages, they are appealing for use in energy conversion and as storage material. Moreover, the emphasis is placed on the function of CDs as nanocatalysts for energy storage devices, and relevant instances are provided to clarify the concepts. These advanced strategies of nanotechnology for energy storage and conversion are expected to play a vital role in promoting sustainability.
1. Introduction
Researchers are concerned about how the preservation of the ecosystem and human health is threatened by the rise in atmospheric pollution and rising energy consumption. To tackle these issues, several technologies are being actively pursued, such as renewable energy sources, alternative energy storage [1,2,3], biofuel cells [4], sustainability [5], advanced nanocatalysts such as two dimensional (2D) materials, one dimensional (1D) materials, zero-dimensional materials, or carbon dots (CDs) [6,7,8,9,10].
In the field of electronics, nanomaterials such as ambipolar graphene quantum dots and other 2D materials play a significant role in excellent carrier mobility in phototransistors with excellent light-harvesting properties. The distinctive structure of 3D graphene allows it to efficiently absorb light while maintaining excellent electrical conductivity [11,12]. Additionally, there has been significant interest in the use of CDs, specifically group IV–VI quantum dots, due to their excellent light-harvesting capabilities in the infrared region. These quantum dots can be conveniently integrated with silicon substrates through a solution process. This integration method offers a practical and efficient approach to incorporating quantum dots into silicon-based devices [12]. CDs emit efficiently in the blue-green range, with the peak shifting towards longer wavelengths as excitation increases. A limited understanding of photoluminescence (PL) in CDs hinders researchers due to the complex structure and variability of the PL centers [13]. Nevertheless, theoretical calculations offer insight into the excited states and electronic structures of different CDs in the context of their optical properties [14].
According to several reports [8,15,16], CDs were first introduced in 2004, and Sun’s research group later gave the name ‘fluorescent CDs’ in 2006 [17]. Xu’s group found CDs during the downstream of single-wall nanotubes (SWNTs) by the gel phoresies of carbon soot [6,8,15,16]. CDs have quasi-spherical even shapes with ultra nano size (almost less than 10 nm) that are primarily made of sp2 or sp3 amorphous carbon along with nanocrystalline graphene layers and some functional groups such as O (almost 5 to 50 wt%), S, −NH2, N, −OH, and −COOH [15,18], which mostly depends on the technique involved [15,16,19]. Due to their ubiquitous optical, electrical, thermal, biological, and physicochemical properties [20], CDs are potential replacements for traditional bio-based nanomaterials in several domains [21,22,23,24]. Additionally, CDs possess excellent electron-transferring abilities due to the uniform dispersion quality of quantum dots [16]. The increased usage of CDs has been hindered by numerous debates due to the rapid publication of emerging nanomaterials, which creates significant obstacles to comprehending their natural properties, thus substantially impeding their widespread adoption [22].
Among the several nanomaterials like graphene, graphene oxide [10,25], and reduced graphene oxide, CDs are becoming a subject of growing interest in various fields and are being examined as a potential substitute for traditional energy storage materials, specifically semiconductor quantum dots, enzymatic biofuel cells, and electronic devices [26] due to their high tunable band gap, higher surface-to-volume ratio, and quantum confinement effect [27].
Some researchers have reported CDs as carbon quantum dots (CQDs)/multi-layered graphene quantum dots (m-GQDs) due to the uncertainty surrounding the classical quantum confinement effect. This is because there is some uncertainty regarding whether the quantum confinement effect is present in CDs or whether their unique properties are due to other factors, such as surface functionalization or defects. Some researchers may use these alternative names to reflect the particles’ properties more accurately and avoid confusion regarding their true nature [28]. The wide range of synthesized processes and materials is essentially the main cause of the diversity of CDs [29]. Currently, the synthesis of CDs is still in its primary stage [16]. Two major techniques are adapted for the synthesis of CDs. Top-down techniques (breaking down large carbon particles into smaller sizes) employ harsh and powerful processes, including electrochemical oxidation [30], arc discharging [31], chemical oxidation [16], and laser ablation [29]. For bottom-up techniques, CDs are formed from small molecules or polymer precursors such as ethylenediaminetetraacetic acid (EDTA) [32], citric acid, ethylene glycol, etc., [33,34,35] under relatively simple and benign conditions, like microwave-assisted pyrolysis, hydrothermal treatment, and ultrasonic reaction [31,33,34]. The drawbacks of the adapted techniques include low yield, time-consuming, synthetic conditions, treatment processes, high cost, and toxicity [36]. This promotes the requirement of a green synthesis technique for producing superior luminous CDs for practical applications [33,37] and heteroatom doping for promoting catalytic activity [36].
Natural sources for CDs include materials like vegetables (onion, ginger, and cabbage) [33] and fruits (orange juice, banana juice, and winter melon) [33,36]. Several other sources include biomass such as betel leaf [37], sugarcane [38], soy milk, bovine serum albumin, gelatin, pomelo peels, bottles, silkworm, chitosan, grape juice, salicin cortex, and papaya powder [33,39].
Numerous reviews advocate the luminance properties of CDs for applications in luminescent devices [8], solar cells [36], bioimaging, fluorescent inks [6], light-emitting diodes [34], sensors [40], supercapacitors, Li-ion batteries, K-ion batteries, sodium-ion batteries, and metal-air batteries [6,40] with significant performance. Extensive research has been dedicated to the development and modulation of CDs as nanocatalysts due to the drive to minimize carbon footprints and advance clean energy conversion and storage technologies in a smooth and rapid manner. It is important to compare the current state-of-the-art technologies to establish a benchmark for progress. This review provides an in-depth understanding of CDs’ potential as nanocatalysts, including their resources, properties, mechanisms, and recent progress in their applications for energy conversion and storage. These applications include using CDs to convert transferring electrons into electricity in biofuel cells for self-powered biosensors or portable electronic devices, as an electrocatalyst accelerates the hydrogen evolution reaction and stores electrical energy in supercapacitors. The article provides valuable insights to encourage further research on the use of CDs as an energy material. The review also provides valuable insights to encourage green synthesized CDs as catalysts and further research prospects and economic analysis that can be used in the advancement of sustainable energy applications.
2. Synthesis Techniques of Carbon Dots and Precursors
Both natural and synthetic carbon-containing substances have been employed as precursors to produce CDs. CD synthesis approaches are mainly classified into two groups: top-down and bottom-up. Several studies advocate the utilization of both techniques for synthesizing CDs [6,16,41,42]. Top-down techniques involve the chemical or physical breakdown of larger carbon substances into smaller CDs. Processes including laser ablation, acidic oxidation, arc discharge, electrochemical synthesis, and others are employed to degrade carbon-rich materials, namely carbon nanotubes (CNTs), graphite rods, activated carbons (ACs), carbon fibers, carbon ash, etc., to ultimately produce CDs. This method favors high crystallinity and well-preserved nanostructures [41,43]. Conversely, the bottom-up approach involves polymerization and oligomers (intermediate products in polymerization reactions) under ambient temperature and pressure to generate CDs. The mechanisms resulting in the excellent luminescence properties of CDs have been discussed [44]. Carbon-based nanoparticles (CNDs) exhibit 0D nanostructures with 10 nm dimensions and a ‘core-shell’ structure consisting of an ordered sp2 core and disordered sp3 shell. Varied sp2/sp3 ratios result from synthesis and environmental factors, affecting optical properties like visible emission, excitation-dependent redshift, and competition with organic dyes and quantum dots. Due to this mechanism, carbon nanodots have varied and controllable emission spectra, making them useful for a variety of applications, including optoelectronics and bioimaging [44].
Amorphous CD structures can be produced with more abundant surface functional groups and multiple doping sites. This is attributed to its excellent performance in chemical sensing and cell imaging applications [36,42]. Glucose, ascorbic acid [45], citric acid [46], ammonium citrate [36], graphite [47], EDTA [32], polyethylene glycol [48], urea, and thiourea [49] are various commonly employed chemical carbon sources as a precursor for preparing CDs. However, these chemicals have resulted in significant environmental, economic, and social challenges due to their reliance on environmentally hazardous solvents and organic compounds with high energy consumption. As a result, significant efforts are being made to adapt the eco-friendly synthesis of CDs employing natural carbon sources, biomass, or less toxic precursors.
2.1. Green Biomass as Carbon Dot Precursors
Over the past decades, due to increased social awareness and a sense of responsibility for sustainability, there has been a noticeable growth in the use of biomass. The precursor biomass materials include a variety of vegetables, leaves, fruit, and organic sources, including proteins, alkaloids, carotenoids, and carbohydrates (Figure 1). Arul et al. (2017) synthesized graphitic-natured nitrogen-doped carbon dots (N-CDs) using dragon fruit (Hylocereus undatus) extract and aqueous liquor ammonia (nitrogen source) using the hydrothermal method that exhibits strong blue fluorescence at 400 nm when excited at 320 nm with an ultra-small diameter of 2.5 nm [30].
Figure 1.
Synthesis techniques and various biomass for CDs.
It was explored that N-CDs emit strong blue luminance and good biocompatibility on both Michigan Cancer Foundation-7 (MCF-7) cells and lymphoblastoid-929 (L-929). They also demonstrated superior catalytic activity for dye reduction, especially methylene blue reduction via sodium borohydride [30,50]. Shen’s group studied probes for Fe3+ detection. They synthesized highly fluorescent CDs from sweet potatoes using a hydrothermal technique, which resulted in CDs with a yield of 8.64%. CDs demonstrated great water dispersibility due to the availability of functional groups on their surfaces. Furthermore, cytotoxicity tests demonstrated that CDs were non-toxic at concentrations up to 100 μg/mL. These fluorescent CDs were appropriate for probes in cell imaging within a range of 1–100 μM and a minimum detectable limit of 0.32 μM [50].
CDs synthesized from water-soluble citric acid were considered to overcome size control and high energy consumption issues and were synthesized from empty fruit bunches (EFB) biochar employing the autoclave hydrothermal technique with a 4 nm average size. Furthermore, it was noted that the growth rate of bacteria co-cultured with these CDs declined with the increase in the concentration of CDs, resulting in up to 100% antimicrobial activity. For E. coli and S. aureus, the minimum inhibitory concentration (MIC) was 60 μg/mL [46]. In a similar investigation, biocompatible copper oxide nanoparticles (CuNPs) were synthesized using Morinda fir extract [51]. It showed higher nociceptive responses and anti-inflammatory potential without any harmful effects, which was confirmed with preclinical research, including peritoneal leukocyte infiltration, carrageenan-induced paw edema, and carrageenan-induced air pouch tests [51]. Researchers in the field of energy have been focusing on the utilization of polymer-CD composites for energy storage devices. Oskueyan et al. (2021) synthesized integrated polypyrrole and graphene carbon dots from carrot juice through a hydrothermal process and in situ polymerization to improve the electrochemical efficiency of the supercapacitor. They developed a high-potential window supercapacitor after integrating a nanocomposite of polyaniline with 10 wt% CDs with polypyrrole-graphene, demonstrating a maximum specific capacitance of 396 F/g under a current density of 5 A g−1 [52].
Additionally, unusual bioresources have been used as carbon precursors for CDs. For example, Zhao et al. (2018) developed a nanosensor probe (detection limit of 0.05 μM) for the diagnosis of uric acid in human serum and urine samples using a pig source as a carbon precursor with a high quantum yield (17.3%) and superior chemical stability. However, some other sources, including food waste materials, bioactive molecules, and microorganisms, are better for the synthesis of CDs. Therefore, the recent developments related to synthesizing CDs from these biosources are a focus [53].
2.2. Synthesis of Carbon Dots from Waste Biomass
The increase in population and the growing demand for horticultural products are major obstacles to effectively managing waste biomass. Nonetheless, the focus has shifted towards utilizing waste biomass to create value-added products such as valuable chemicals, biofuels, bio-oil [54], nano-biochar [55], energy storage products [56], etc. Waste biomass can be considered a sustainable and affordable material for the synthesis of CDs. Fe3+ ions could be detected with the CDs obtained from onion waste [33]. These water-dispersible CDs were employed as blue, green, and red fluorescent probes for the detection of Fe3+ ions via fluorescence quenching under different conditions, including a wide range of molarity (0–20 mM), pH, high ionic strength, and continuous irradiation with a detection limit of 0.31 mM for Fe3+ ions. It had good biocompatibility for both cancerous (HeLa) and normal (HEK-293) cells [33].
Likewise, CDs were produced using sugarcane molasses as a carbon source from industrial waste [38]. These CDs had a small size of 1.9 nm and a quantum yield of 5.8%. This study found that the illuminance quenching intensity of the CDs decreased upon the addition of Fe3+ or by giving them a sunset yellow color. Furthermore, the researchers assessed the biocompatibility of CDs in vivo and in vitro and discovered their ability to perform bioimaging in MCF-7 cells [38]. To create smaller N-CDs, Pankaj et al. (2018) synthesized EDTA as a nitrogen source and sodium lauryl sulfate from waste-candle soot. The researchers were able to decrease the size of N-CDs to as small as 2−5 nm to selectively detect Fe3+ and Hg2+ ions. By maintaining a pH level of 4–5, a functional group with a negative net surface charge (−10.4 mV) was successfully produced [57]. Thakur et al. (2019) also utilized pyrolysis to synthesize CDs from the waste pulp of Citrus limetta for the detection of Fe3+ ions. The CDs had an ultra-small size range of 4–7 nm and achieved the highest quantum yield of 63.3% among other green-synthesized CDs. These CDs showed promising results in various applications, including electrolysis during the photoelectrochemical current density of 6 mA/cm2 for water splitting, methylene blue reduction, and antibacterial activities against S. aureus and E. coli [58].
2.3. Microorganisms and Bioactive Molecules as a Carbon Dot Precursor
Microorganisms are regarded as efficient materials for synthesizing various nanomaterials such as ZnO, Cu2O, Au, CdS, and MgO nanoparticles [59]. This method is remarkable for environmental protection and minimizes waste. Recently, microorganisms like yeast, bacteria, cyanobacteria, algae, actinobacteria, etc., and bioactive molecules such as thiamine pyrophosphate (Vitamin B1), malonic acid, ascorbic acid, gelatine, dopamine, bovine serum albumin (BSA), etc., have also been utilized as green precursors in synthesizing CDs [9,60,61,62]. Wu et al. (2018) synthesized CDs by a novel one-step approach from yeast extract powder through the hydrothermal method at 160 °C with a high yield of 65.8% and a size of 3.36 nm. They achieved good dispersibility in water. They also prepared CDs integrated with polyvinyl alcohol (PVA). It showed good water-induced shape memory performance at the optimum temperature (room temperature). Additionally, it can be synthesized economically on an industrial scale without harming the environment [9].
A similar study was conducted by Bakhshi et al. (2016) on the cost-effective, eco-friendly, and replicable production of cadmium sulfate carbon dots (CdS-CDs) with a particle size of 4.4 nm at room temperature using Bacillus licheniformis ptcc1320 as a surfactant [63]. Lin et al. (2018) reported the formation of biofilms and their detrimental effects on biomedical and industrial applications. In their investigation, carbon dots from Lactobacillus plantarum biomass were prepared through single-step hydrothermal carbonization without using any chemicals. These CDs demonstrated low cytotoxicity and good biocompatibility. Additionally, it has been demonstrated that these CDs effectively inhibit the formation of biofilms by E. coli without hindering the growth of E. coli, thus overcoming the cytotoxicity issues associated with many current antibiofilm agents and becoming a novel and safe approach for biofilm treatment [60].
Gong et al. (2017) fabricated a fluorescent probe using N, S, and P co-doped CDs derived from Saccharomyces cerevisiae via the hydrothermal pyrolysis method. This probe could detect manganese (VII) with a detection limit of 50 nmol/L and L-ascorbic acid (L-AA) with a detection limit of 1.2 μmol/L in medicinal herb, river water, and tap water samples through label-free and ‘on-off-on’ detection techniques. Additionally, it is worth developing an ‘AND’ logic gate using the same probe for environmental monitoring, disease diagnosis, and cellular labeling [64]. Investigations are being accomplished on different bioactive molecules to achieve two objectives: first, to minimize the severity of the synthesis conditions, and second, to synthesize particles with ubiquitous properties [62]. Ganjkhanlou et al. (2022) synthesized dual fluorescence carbon dots. These CDs, as nanosensors, have immense promise and enormous potential in the fields of life and materials sciences [65].
CDs were synthesized from bioactive molecules such as glutathione and formamide through the solvothermal method at 180 °C [65]. They observed two fluorescence CDs (red-shedding porphyrin and blue-shedding carbon dots) as synthesis products. They separated a mixture of red-emissive and blue-emissive kaolinite [65]. To enhance the accumulation of astaxanthin in microorganisms, Ghose et al. (2017) prepared N-CDs derived from carbonized BSA. The carbon dots exhibited blue emission with a quantum yield of up to 44%, which surpasses the CDs synthesized using bioactive molecules. In Haematococcus pluvialis culture, astaxanthin (dihydroxy-3,3′ dioxo-4,4′ bêta-carotène) production increased by double (66 mg/L) in just one week after adding the N-CDs (1 mg/L), contrary to two weeks during the reddening stage for the control (29 mg/L) [62]. These results proved their photostability and reusability because their fluorescence spectra displayed no crucial variation after a month of continuous irradiation. N-CDs have a promising future in the natural astaxanthin industry and other value-added products produced by microorganisms [62]. Similarly, Amjad et al. (2019) prepared semiconductor quantum dots (QDs) from bovine gelatin through a hydrothermal technique to overcome their toxicity. Surprisingly, the resulting carbon bovine gelatin nanotubes exhibited QDs-like fluorescence characteristics despite their size exceeding (59.45–67 nm) the Bohr exciton radius.
CDs were also prepared from Pectinodesmus sp. algal biomass under the same hydrothermal conditions (200 °C and 3 h), resulting in CA-PHM3algae nanodots [66]. A comparison of CG and CA-PHM3algae nanodots revealed that surface chemical composition played a significant role in determining their surface states and PL properties. CGs were found to be non-toxic and suitable for bacterial cells and imaging plants, while both CA-PHM3algae and CGs showed promising anticancer properties against HCC 1954 (breast cancer) and HCT 116 (colorectal cancer) cell lines [66].
The value-added utilization of waste biomass for the synthesis of CDs, an affordable and environmentally friendly resource, not only addresses the pressing need for large-scale synthesis of CDs but also drives the advancement of sustainable management practices. However, it is important to consider certain aspects considering the recent progress in the green synthesis of CDs. First, most of the current synthetic methods have been carried out on a laboratory scale. The production of CDs on a larger scale using these green precursors has not been extensively explored, leaving uncertainty regarding whether the synthesized samples would exhibit the same unique properties observed in lab-scale preparations. Considering the high demand for CDs in numerous applications, large-scale production from green sources would have significant economic and environmental implications.
Table 1 lists a variety of biomass precursors that have been mentioned in the literature and have been used to synthesize CDs.
Table 1.
Synthesis methods, applications, and derivative CD types from various precursors.
3. Properties and Functionalization of Carbon Dots
Jiang et al. (2022) and Yao et al. (2019) have noted that CDs can be produced using various precursors and methods, resulting in a wide range of sizes, morphologies, and chemical structures. This complexity leads to significant variations in the physicochemical properties of CDs [40,75]. Good dispersibility is essential for the processing and application of CD solutions. Most carbon nanodots are hydrophilic due to oxygen-containing functional groups (−OH, −COOH, CO, etc.) that are either derived from precursors or generated during the synthesis procedure. The ability to manipulate the wettability of CDs in response to environmental factors has been achieved, which could broaden the range of applications for carbon dots [15,76]. Kumar et al. (2022). elevated the electron recovery by adding CDs, which were synthesized from peanut shells through pyrolysis at optimum conditions (250 °C, 2 h) into the microbial fuel cell. In the investigation, CDs were employed as an oxidizing agent for organic substrate (acetate) at the anode, and by dispersing CDs, the greater surface area of CDs in the anode chamber enhanced the conductivity of anolyte by reducing the ohmic overpotential [76].
Ramanavicius and Ramanavicius (2020) prepared integrated red-emitting CDs with MXenes and found that DNA has a significant role in dispersing the Ti3C2-based nanosheets and in the creation of Pd/Pt and Pd structures. The Ti3C2-based MXene provided conductive support. A novel electrochemical biosensor (MXene/DNA/Pd/Pt/GCE) electrode was fabricated for the measurement of dopamine, with a detection range of 0.2–1000 mM and a minimum limit of detection of 30 nM [77]. Despite having a wide range of chemical structures, most CDs display a similar UV-Vis absorbance spectrum, with a pronounced absorption band that decreases from the UV to the visible region. However, some CDs are visibly distinct due to various precursors in different solvents [17]. CDs exhibit their optical characteristics through absorption and fluorescence measurements. Specifically, their absorption properties in the UV range (230–320 nm) are used to describe their optical properties. The peak absorption at 230 nm is primarily due to the π-π* transition of aromatic C-C bonds in the carbon core of the CD. Additionally, a smaller absorption peak (shoulder peak) at 300 nm is attributed to the n-π* transition of C=O bonds [78,79]. This absorbance is attributed to the p-p* transitions of conjugated electrons and n-p* transitions from oxygen or heteroatoms. The shape and intensity of the curve can be adjusted through surface modification or heteroatom doping employing the same precursors [78,80].
Dias et al. (2019) reported three distinct CDs from kiwi, pear, and avocado fruits through the same hydrothermal approach. These showed a high fluorescent intensity range of 470–542 nm [81]. Bioenergy generation through microbial extracellular electron transfer (EET) was reported by Zhang et al. (2022). The PL intensity of CDs significantly decreased after the reaction between CDs and cytochrome due to the accumulation of CDs induced by cytochrome. The UV-Vis absorption spectra were used to confirm the changes in the cytochrome with CDs. The characteristic Soret band (408 nm) and Q-band (529 nm) of native cytochrome remained unchanged even after adding CDs, which indicates that the structure of hemoprotein remained pristine, which could lead to new applications in the coming year [82].
Tripathi et al. (2022) prepared anode CDs coated with Fe (II, III) oxide (Fe3O4) for applications in microbial fuel cells. The obtained maximum PL was 1 mg/cm2, which was higher than the graphite anode [83]. According to Guo et al. (2019), a new way to modify the bacteria’s surface was achieved using positively charged N, S-doped carbon dots (m-NSCDs), which can attract negatively charged bacteria through electrostatic attraction. These m-NSCDs not only improve the bacteria’s conductivity but also act as efficient photosensitizers that enhance biocatalysts under light, leading to a significant increase in EET during bio-anodic oxidation techniques in microbial fuel cells. Additionally, doping both S and N on carbon dots via carbonization and etching of hair fiber via H2SO4 resulted in good luminescence stability [84].
The minimal toxicity of CDs is crucial for their successful biological applications in various biomedical fields. Typically, CDs have low toxicity at low concentrations, which is mainly due to their bulk form, and at this size, they either decompose or are eliminated by the excretory system [85]. In certain situations, the toxicity of CDs is greatly heightened when exposed to an external stimulus [86]. Various types of anodic materials have been reported to enhance electron transfer rates, wastewater treatment, and energy-generation processes in microbial fuel cell (MFC) systems [87]. The significant surface area of the anodic substances has a crucial role in achieving high efficiency in removing pollutants and generating a current, as it promotes the growth of bacteria at the anode’s surface, whereas graphene-based CDs cannot be preferred because of their poisonous effect on bacteria [88].
The formation of a biofilm indicates that microbes can strongly adhere and have good biocompatibility, which helps with extracellular electron transfer and improves energy conversion efficiency. However, if the biofilm becomes too thick, the mass diffusion coefficient may be negatively impacted. Therefore, it is necessary to investigate the optimal thickness of the biofilm to improve the efficiency of MFCs [89]. Sn-based CD alloys have been extensively studied as anodic substances in MFCs because of their electrocatalytic activity and biocompatibility with living organisms [89]. The research was conducted for the synthesis, characterization, properties, and bioimaging capabilities of CDs derived from widely cultivated fruits such as pear (Pyrus), avocado (Persea americana), and kiwi (Actinidia) [81]. Among them, they found that kiwi-derived CDs were highly toxic for zebrafish embryos and the epithelial cell lines of humans [81]. CDs possess a remarkable combination of optical, surface, and biocompatibility properties and are thus expected to have a wide range of potential uses in industries including biomedicine, energy storage, environmental sensing, electrochemical electrocatalysis, and optoelectronics.
4. Carbon Dots as Nanocatalysts in Energy Storage and Conversion
4.1. Biofuel Cells
Biofuel cells (BFCs) have shown great potential as a power source for portable biomedical devices and self-powered biosensor portable electronic devices by transferring electrons between enzymes and electrodes as well as the degradation of organic substrates [18,90,91,92]. This is due to their superior efficiency, volumetric power density, biocompatibility, low working temperature, and neutral pH [93,94,95]. Mostly, BFCs’ power supply capacity is in the range of 10 µW–450 mW with a voltage range of 0.5–1 V [93,95] and a power density of 3.7 mW/cm2 [91]. However, the major limitations of the technology include limited mass transportation, the minimal utility of enzymes, low durability and lifetime, and slow electron transfer [91,94,96].
Bioenergy generation through microbial extracellular electron transfer (EET) was reported by Zhang et al. (2022). They reported that by incorporating CDs, the efficiency of electron transfer could be enhanced five times from the pure dissimilatory metal-reducing bacteria (DMRB) due to the enhancement in biofilm immobilization and riboflavin secretion [82]. To create advanced BFCs, direct electron transfer (DET) between electrodes and redox enzymes is the best solution. It provides higher stability and better power supply without a redox mediator at an optimal voltage [79,90]. Since it only relies on the position and direction of the active site within the protein, DET requires an immediate connection between the enzyme and the electrode, which is not always possible [92]. Barelli et al. (2019) reported that during successful DET, the tunneling distance should be about 1.5 nm. The effective DET electron transfer process demonstrated that the highly conductive, porous macro or nanofabricated electrode material is the turning point for enhancing the number of wired enzymes per unit volume [18,90].
Earlier studies have explored important avenues for the efficient utilization of carbon-based materials such as CDs, nanofibers, graphene, nanowires, and carbon black in BFCs for implantable and low-power device applications [90,91,97].
Researchers have developed advanced nanoelectrode materials and immobilization techniques for enhancing the efficiency of BFCs (Figure 2) and biosensors [26]. Recently, nanoscale technologies have addressed the issue of the low electron transfer efficiency between the enzyme and electrode surface, along with permitting the assimilation of a higher enzyme load to improve the efficiency of kinetic processes in BFCs through modified fabrication. Similarly, Wu et al. (2017) prepared CDs from candle soot to design a laccase-based electrode. It was reported that the laccase activity was 220 U/mg, and the CD immobilizing matrixes facilitated high methanol oxidation through direct electron transfer at the anode and oxygen reduction into H2O at the laccase-based cathode. They achieved a better power density of 68.7 ± 0.4 μW/cm2 and an open-circuit voltage (OCV) of 0.71 ± 0.02 V after fabricating the immobilizing matrixes of CDs [18].
Figure 2.
Schematic illustration of the full-cell configuration with CDs as electrocatalysis.
Zhao et al. (2015) developed a biosensor for glucose detection using direct electron transfer reactions of glucose oxidase (GOx) and bilirubin oxidase (BOD) immobilized on CDs. The biosensor has a detection range of 0–0.64 mM and an optimum high sensitivity of 6.1−1 μA mM with an optimal detection limit of 1.07 μM. Additionally, the fast DET high rate constant of the CD electrodes trapped in GOx was 6.28 ± 0.05 s, and the apparent Michaelis–Menten constant for dextrose affinity was as low as 0.85 ± 0.03 mM [92]. Further, due to their excellent direct bioelectrocatalytic performance, CDs were discovered to be effective for the development of bioelectrochemical sensors and BFCs. Using CD electrodes, a DET-type glucose–air enzymatic BFC was successfully modified employing CD electrodes entrapped with GOx that oxidized glucose at the anode. With an OCV maximum voltage of 0.93 V and a maximum power density of 40.8 μW/cm2, BOD reduced oxygen at the biocathode.
According to these findings, CDs hold potential as materials for immobilizing enzymes and creating effective bioelectrochemical devices [92]. Through in situ coupling with MFCs, Zeng et al. (2019) prepared a novel sustainable self-energy conversion system to produce renewable CDs. It was found that the generation of CDs highly enhanced electricity production [12]. So far, few studies have been conducted on CD-based BFCs. However, the potential of CDs in BFCs is yet to be realized. Due to their ultra-nano size, CDs have the potential to integrate with the biocatalysts and directly contact their active centers. By capitalizing on these exceptional qualities, biomass CD (BCD)-based BFCs can be developed with better performance.
4.2. Electrocatalysts for Energy Conversion
The performance of CDs as carbon nanomaterials for electrocatalysts has been advocated due to their high dispersibility in polar solvents, strong coordination, and distinctive electron transfer ability [98]. Additionally, CDs can be combined with other nanomaterials or metal to create 2D and 3D nanostructures along with −COOH, −NH2, −OH, or other similar functional groups via self-crosslinking or splicing, hydrophilic terminals, or covalent bonds with rich edge structures. Thus, it accelerates the hydrogen evolution reaction (HER) by significantly expanding the three-phase boundary where reactants, electrolytes, and electrons converge [87].
Moreover, the flexible carbon structure and the surface chemistry of the CDs allow optimization of the electrocatalysts based on CDs while also promoting the development of advanced biofuel cells [98,99]. The CD-based electrocatalysts have used several synthetic techniques, including hydrothermal treatment, calcination, electrodeposition, and reflux. These catalysts can be classified as metallic or non-metallic based on the availability of the metal components [42,98,99].
HER is an extensively researched topic in the electrocatalyst field and involves an uncomplicated proton–electron transfer process without any accompanying reactions. A three-electrode system (working, reference, and counter electrode) is used to measure HER. The reference electrode’s potential is measured via the reference electrode [56].
According to Volmer’s equation, the intermediate step entails the adsorption of hydrogen onto the electrode’s surface. Electronic interactions and thermodynamics with catalyst materials have a significant impact on hydrogen generation.
The binding energies are determined by the kinetics and thermodynamics of the reactions occurring on the electrode surface, as well as other factors such as solvent contribution. In the case of transition metal catalysts, the catalyst performs according to the Sabatier principle [100].
Once absorbed, the HER proceeds through the Heyrovsky or Tafel equation, depending on the pathway. The following Volmer–Heyrovský mechanism involves the reaction of the HER electrode system [56,100].
H+ + e− → H (Proton-coupled electron transfer step (PCET))
H+ + e− + H → H2 (Heyrovsky reaction)
H + H → H2 (Tafel reaction)
In the following studies, to facilitate the HER process, a suitable catalyst is necessary for lowering the overpotential and activation energy. Pt metal is a frequently used catalyst for HER due to its long lifespan and minimal overpotential. However, due to its high cost and limited availability, researchers are working on developing suitable, cost-effective substitute catalysts for HER [101]. Moreover, the use of Pt as a catalyst in an alkaline environment is hindered by hydroxyl ion (−OH) poisoning, necessitating the substitution of a highly stable and low overpotential Pt catalyst. In this context, CDs, along with their metallic and non-metallic counterparts, could serve as an efficient electrocatalyst [56,101,102].
Developing an effective electrocatalyst to facilitate HER from water is a significant but difficult task that must be addressed to facilitate the ongoing energy crisis. Yang et al. (2015) prepared CDs (TiO2/CD nanohybrids) for the development of an alkaline electrocatalyst for HER (1 M KOH). Hybrid facile fabrication of a nickel nanoparticle/carbon quantum dot (Ni/CQD) displayed outstanding catalytic activities for HER, with an initial potential the same as the Pt wire and a low Tafel slope of 98 mV/dec, due to the Ni-O-C interface between Ni nanoparticles and CDs. The stability of the Ni/CDs hybrid was also found to be high, as is observed by the negligible current loss after 1000 cyclic voltammetry. Additionally, the Ni/CDs hybrid exhibited improved catalytic performance and UV-light illumination, with a lower Tafel slope of 77 mV/dec [101].
Moreover, it is also crucial to establish techniques for the precise characterization and quantification of active sites in reactions 1, 2, and 3. However, the number and type of active sites are often not reported, and determining turnover frequency can be a challenging task. It is crucial to conduct meticulous investigations of catalytic activity using flat electrodes with controlled catalyst density, develop electrodes with well-defined active sites, and explore techniques for quantifying active sites that are critical for determining the true activity of catalytic materials [100]. Overall, hybrid CDs are potentially efficient electrocatalysts for HER, which could contribute to the development of sustainable energy solutions.
Studies focusing on the preparation methods and applications of various CDs in different energy storage and conversion fields are summarized in Table 2.
Table 2.
Reported data on the utilization of various CD composites and their application in energy conversion and storage.
4.3. Supercapacitor
Supercapacitors or ultracapacitors are based on redox reactions to store energy (Figure 3). There are three types of supercapacitors based on the type of electrochemical reactions occurring: pseudo-capacitors (PCs)/Faraday capacitors, electrostatic double-layer capacitors (EDLCs), and hybrid ion capacitors (HICs) that combine the two capacitors [40]. When conducting polymers, metal oxides, or metal nitrides are used as electrode materials in a pseudo-capacitor, a reduction–oxidation reaction takes place, resulting in a higher transfer of electron charges between the electrode and the electrolyte, resulting in a higher electrochemical pseudo-capacitance. Therefore, compared to electric double-layer capacitances (EDLCs), PCs and HICs perform better [40,104].
Figure 3.
The schematic mechanism illustration of fabricated asymmetric supercapacitor devices based on CDs.
Despite the advancements in renewable energy storage devices, high-capacity HICs like potassium-ion capacitors, sodium-ion capacitors, and lithium-ion capacitors face challenges in achieving high energy density and power density due to an imbalance in capacity and kinetics between the anode and cathode materials. [104,105,106]. In the pursuit of supercapacitors that can charge and discharge faster and have higher energy densities, it has become crucial to explore various high-performance electrode materials. To achieve this, different approaches have been adopted, such as utilizing nanomaterials and modifying existing electrode materials, creating materials based on the compatibility of electrolytes and electrodes, and exploring novel materials [43,106]. Previous reports advocate that the addition of CDs to composites can improve their conductivity and reduce the electrolyte diffusion length during the charge–discharge process. Some composites that combine CDs and metal chalcogenides were successfully synthesized with promising results.
Wang et al. (2020) investigated the effect of CDs on a rechargeable supercapacitor with light assistance. They created CDs by utilizing pro-anthocyanidin precursors for light-assisted supercapacitors (OPC-CDs-700), resulting in the generation of CDs that act as a photoactive medium to stabilize charge under light illumination. This allows for greater charge accumulation on the material surface and the storage of more energy under light illumination. The researchers were able to achieve a 54.4% increase in specific capacitance (312 F/g at 0.1 A/g) in light conditions as compared to dark conditions. This was due to CDs providing a larger specific surface area for OPC-CDs-700, which promotes mass transport and charge transfer [105].
Utilizing CDs with integrated graphene to create various three-dimensional porous structures is a proven effective approach for preventing graphene agglomeration, improving electrical conductivity and mechanical strength, and increasing wettability. Jin et al. (2018) synthesized nitrogen and oxygen-co-doped carbon nanodots (N-O-CDs) from discarded fiberboards using a sequence of carbonization, acid treatment, centrifugation, and dialysis purification procedures. These CDs could be integrated with graphene oxide to form a graphene hydrogel for supercapacitor electrodes. The composite hydrogel was created at an ideal mixing ratio with the desired porosity and optimum loading weight of 200 g. The composite hydrogel electrode displayed a specific capacitance of 335.1 F/g at 1 A/g and excellent mechanical strength, retaining approximately 90.6% of its capacitance after 500 bending and unbending cycles. Furthermore, the flexible symmetric supercapacitor demonstrated cycling stability of 83.4% after 10,000 charge/discharge cycles at 5 A/g with a high specific capacitance of 121.0 F/g [107].
Numerous studies have concentrated on exfoliating layered materials and restacking the 2D exfoliated nanosheets such as MoS2 to form electrodes, as well as the enhanced electrochemical response, to promote higher conductivity with the formation of metallic octahedral structures during the intermediate state (1T-phase) and account for the enhancement of the electrochemical performance of the electrode [108]. Gao et al. (2016) investigated the utilization of thiourea as a precursor for N-doped CDs, confirming the effect of hindering the agglomeration of MoS2 and increasing the interlayer spacing of MoS2 through the generation of NH3 during the hydrothermal process. The integration of MoS2/reduced graphene oxide at polyaniline (MoS2/RGO @ PANI) resulted in a synergistic effect that led to exceptional energy storage performance, with remarkable capacitive value (1224 F/g at 1 A/g), excellent rate capability (721 F/g at 20 A/g), and a high level of cyclic stability of 82.5% after 3000 cycles [92]. Additionally, the symmetric cell that utilized MoS2/RGO @ PANI demonstrated favorable capacitive properties (160 F/g at 1 A/g) along with impressive energy (22.3 W h/kg) and power density (5.08 kW/kg) [109].
As aforementioned, CD-based supercapacitors and graphene at metal–organic frameworks (graphene @ MOF) integration with CDs can improve the properties of electrodes by merging physical and charge storage mechanisms into one. This combination can provide an ideal mixture of energy and power density due to EDLC from graphene-contenting materials and the pseudo-capacitance from metal-based MOFs [94].
4.4. Photocatalysts
In photocatalysis, CDs have proven to be adaptable materials with a variety of uses. They are extremely useful for capturing solar energy in a variety of catalytic processes due to their special qualities. The wide absorption spectrum extending into the visible range is one of the main advantages of being able to use sunlight effectively. This characteristic distinguishes CDs from traditional semiconductor photocatalysts such as titanium dioxide (TiO2) and enables them to effectively catalyze environmentally important reactions. CDs are used in environmental remediation to degrade colors and medicines and to break down organic contaminants in wastewater [110]. CDs are also essential for hydrogen generation via water splitting, which helps produce hydrogen in a greener manner. In the process of reducing carbon dioxide, CDs help to convert CO2 into organic molecules or valuable hydrocarbons, facilitating the capture and usage of CO2, and are used to increase solar cell efficiency, which helps convert sunlight into power. Furthermore, their antimicrobial qualities make them useful for sterilizing and purifying water. When exposed to light, they help break down organic pollutants and are integrated into self-cleaning surfaces [111]. Additionally, CDs participate in selective photoredox reactions, providing excellent selectivity in the production of different compounds and medications. Researchers continue to find ways to modify CDs to further improve photocatalytic efficiency, which would increase the number of sustainable and energy-efficient processes in which they can be used [110,111].
5. Economic Analysis
Due to their potential to transform chemical energy stored in biofuels into electrical energy, biofuel cells have emerged as a promising renewable energy technology. Carbon-based catalysts improve biofuel cell performance by facilitating efficient electrochemical processes. BCDs made from sustainable biomass materials offer enormous potential as a cost-effective and environmentally friendly alternative to traditional catalytic materials. However, there is a lack of detailed economic analysis of BCDs in biofuel cell applications. It is very important to address the economic feasibility of employing BCDs in commercial biofuel cells.
The economic study is divided into three primary steps: production cost estimation, scalability assessment, and prospective economic benefit analysis. First, the cost of BCD manufacturing is determined by considering the costs of raw biomass sources, synthesis processes, purification techniques, and post-treatment operations. Energy consumption, labor costs, and equipment investments are all considered. Second, scalability is evaluated by examining BCD production capacity and associated costs at various sizes, from laboratory to industrial. Finally, the potential economic benefits of using BCDs in biofuel cells are assessed by considering parameters such as increased energy conversion efficiency, longer lifespan, lower maintenance costs, and overall system performance. The economic study demonstrates that the choice of biomass feedstock, synthesis process, and purification techniques has a substantial impact on the cost of producing BCDs. However, because of the abundance and low cost of biomass feedstocks, BCDs have numerous cost advantages over standard catalytic materials. Furthermore, the scalability analysis suggests that BCD production may be easily scaled up without significant cost increases. Increased power output, lower fuel use, and extended lifespan of biofuel cells are all potential economic benefits of BCD adoption, resulting in cost savings and improved overall system efficiency. BCD implementation can result in enhanced energy conversion efficiency, lower operational costs, and increased sustainability. To realize their full economic potential in commercial biofuel cell applications, further research and development activities should focus on optimizing synthesis techniques, discovering novel biomass feedstocks, and improving BCD performance.
6. Conclusions and Prospects
Recent green synthesis of CDs was emphasized using biomass materials, particularly novel, contemporary, and more sustainable precursors. To promote sustainability, these methods rely on the use of renewable resources, including biomass, biowaste, and microorganisms, which are both inexpensive and environmentally friendly. Meanwhile, the current synthesis processes have only been conducted on a small scale. Therefore, it is still unclear whether the unique properties exhibited by the lab-scale preparation of CDs can be replicated in large-scale production using green sources. If large-scale production can be achieved, it would have significant economic and environmental benefits, as CDs are highly sought-after materials for many applications. Various factors affecting CDs, including their size, functional groups, the crystallinity of the carbon core structure, and other factors, decisively influence their properties. To deal with these, further deep studies of the structure-activity relationship of CDs are needed.
CDs offer distinct advantages and enormous potential for clean energy conversion and energy storage. However, the complex mechanism of CDs as an electrocatalysis material in the energy storage field makes it challenging. To address this challenge, new in situ analysis and kinetic characterization methods should be introduced for utilizing CDs as an excellent model. Although CDs might be the most efficient material for energy applications, they have provided valuable insights into catalytic mechanisms and catalyst design principles. With the continued development of advancement, BCDs can display distinctive optical and electrical features with electrocatalytic properties. These properties make BCDs a fitting choice for various applications in the sustainable energy domain, such as enhancing energy conversion efficiency by serving as nanocatalysts for electrodes, mediators, and electrocatalysts for water splitting in hydrogen fuel production. This review presents an idiosyncratic opportunity in the field of energy to expand the possibility of green synthesized CD nanocatalysts with multifunctional properties. Based on current global research, CDs as modulated nanocatalysts with potential applications in clean and green energy are an exciting and quickly evolving field that holds great promise for promoting sustainability.
Author Contributions
A.S.: writing original draft. S.R.K.: writing—review and editing. M.S.: writing—review and editing. B.S.K.: writing—review and editing. All authors have read and agreed to the published version of the manuscript.
Funding
This research was supported by the National Research Foundation of Korea (NRF-2019R1I1A3A02058523).
Data Availability Statement
No new data were created or analyzed in this study. Data sharing is not applicable to this article.
Conflicts of Interest
The authors declare no conflict of interest.
References
- Bu, Y.; Kim, H.K.; Lee, J.S.; Jang, H.G.; Jeong, J.H.; Chun, S.W.; Sharma, M.; Kim, B.S. Improvement of biodegradable polymer film properties by incorporating functionalized few-layer graphene. Food Packag. Shelf Life 2023, 40, 101205. [Google Scholar] [CrossRef]
- Sharma, M.; Das, P.P.; Purkait, M.K. Chapter 16—Energy storage properties of nanomaterials. In Advances in Smart Nanomaterials and Their Applications; Husen, A., Siddiqi, K.S., Eds.; Elsevier: Amsterdam, The Netherlands, 2023; pp. 337–350. [Google Scholar] [CrossRef]
- Sharma, M.; Das, P.P.; Chakraborty, A.; Purkait, M.K. 29—Extraction of clean energy from industrial wastewater using bioelectrochemical process. In Resource Recovery in Industrial Waste Waters; Sillanpää, M., Khadir, A., Gurung, K., Eds.; Elsevier: Amsterdam, The Netherlands, 2023; pp. 601–620. [Google Scholar] [CrossRef]
- Sharma, M.; Das, P.P.; Sood, T.; Chakraborty, A.; Purkait, M.K. Reduced graphene oxide incorporated polyvinylidene fluoride/cellulose acetate proton exchange membrane for energy extraction using microbial fuel cells. J. Electroanal. Chem. 2022, 907, 115890. [Google Scholar] [CrossRef]
- Singh, A.; Kushwaha, A.; Goswami, S.; Tripathi, A.; Bhasney, S.M.; Goswami, L.; Hussain, C.M. Roadmap from microalgae to biorefinery: A circular bioeconomy approach. In Emerging Trends to Approaching Zero Waste: Environmental and Social Perspectives; Elsevier: Amsterdam, The Netherlands, 2021. [Google Scholar] [CrossRef]
- Perumal, S.; Atchudan, R.; Edison, T.N.J.I.; Lee, Y.R. Sustainable synthesis of multifunctional carbon dots using biomass and their applications: A mini-review. J. Environ. Chem. Eng. 2021, 9, 105802. [Google Scholar] [CrossRef]
- Sharma, M.; Chakraborty, A.; Kuttippurath, J.; Yadav, A.K. Potential Power Production from Salinity Gradient at the Hooghly Estuary System. Innov. Energy Res. 2018, 7, 210. [Google Scholar] [CrossRef]
- Zuo, P.; Lu, X.; Sun, Z.; Guo, Y.; He, H. A review on syntheses, properties, characterization and bioanalytical applications of fluorescent carbon dots. Microchim. Acta 2015, 183, 519–542. [Google Scholar] [CrossRef]
- Wu, S.; Li, W.; Zhou, W.; Zhan, Y.; Hu, C.; Zhuang, J.; Zhang, H.; Zhang, X.; Lei, B.; Liu, Y. Large-Scale One-Step Synthesis of Carbon Dots from Yeast Extract Powder and Construction of Carbon Dots/PVA Fluorescent Shape Memory Material. Adv. Opt. Mater. 2018, 6, 1701150. [Google Scholar] [CrossRef]
- Pham, P.V.; Bodepudi, S.C.; Shehzad, K.; Liu, Y.; Xu, Y.; Yu, B.; Duan, X. 2D Heterostructures for Ubiquitous Electronics and Optoelectronics: Principles, Opportunities, and Challenges. Chem. Rev. 2022, 122, 6514–6613. [Google Scholar] [CrossRef]
- He, Z.; Zhang, S.; Zheng, L.; Liu, Z.; Zhang, G.; Wu, H.; Wang, B.; Liu, Z.; Jin, Z.; Wang, G. Si-Based NIR Tunneling Heterojunction Photodetector With Interfacial Engineering and 3D-Graphene Integration. IEEE Electron Device Lett. 2022, 43, 1818–1821. [Google Scholar] [CrossRef]
- Zeng, L.; Li, X.; Fan, S.; Li, J.; Mu, J.; Qin, M.; Wang, L.; Gan, G.; Tadé, M.; Liu, S. The bioelectrochemical synthesis of high-quality carbon dots with strengthened electricity output and excellent catalytic performance. Nanoscale 2019, 11, 4428–4437. [Google Scholar] [CrossRef]
- Mocci, F.; Engelbrecht, L.d.V.; Olla, C.; Cappai, A.; Casula, M.F.; Melis, C.; Stagi, L.; Laaksonen, A.; Carbonaro, C.M. Carbon Nanodots from an In Silico Perspective. Chem. Rev. 2022, 122, 13709–13799. [Google Scholar] [CrossRef]
- Langer, M.; Paloncýová, M.; Medveď, M.; Pykal, M.; Nachtigallová, D.; Shi, B.; Aquino, A.J.A.; Lischka, H.; Otyepka, M. Progress and challenges in understanding of photoluminescence properties of carbon dots based on theoretical computations. Appl. Mater. Today 2021, 22, 100924–100951. [Google Scholar] [CrossRef]
- Kang, Z.; Lee, S.T. Carbon dots: Advances in nanocarbon applications. Nanoscale 2019, 11, 19214–19224. [Google Scholar] [CrossRef] [PubMed]
- Kurian, M.; Paul, A. Recent trends in the use of green sources for carbon dot synthesis-A short review. Carbon Trends 2021, 3, 32. [Google Scholar] [CrossRef]
- Cui, L.; Ren, X.; Sun, M.; Liu, H.; Xia, L. Carbon dots: Synthesis, properties and applications. Nanomaterials 2021, 11, 3419. [Google Scholar] [CrossRef]
- Wu, G.; Gao, Y.; Zhao, D.; Ling, P.; Gao, F. Methanol/Oxygen Enzymatic Biofuel Cell Using Laccase and NAD+-Dependent Dehydrogenase Cascades as Biocatalysts on Carbon Nanodots Electrodes. ACS Appl. Mater. Interfaces 2017, 9, 40978–40986. [Google Scholar] [CrossRef] [PubMed]
- Darinel, S.; Landa, T.; Kumar, N.; Bogireddy, R.; Kaur, I.; Batra, V.; Agarwal, V. Heavy metal ion detection using green precursor derived carbon dots. iScience 2022, 25, 103816. [Google Scholar]
- Devadas, B.; Imae, T. Effect of Carbon Dots on Conducting Polymers for Energy Storage Applications. ACS Sustain. Chem. Eng. 2018, 6, 127–134. [Google Scholar] [CrossRef]
- Duarah, P.; Das, P.P.; Sharma, M.; Purkait, M.K. Recent Advances in Dye Removal Technologies by Designer Biochar. In Designer Biochar Assisted Bioremediation of Industrial Effluents; CRC Press: Boca Raton, FL, USA, 2022; pp. 223–239. [Google Scholar]
- Essner, J.B.; Kist, J.A.; Polo-Parada, L.; Baker, G.A. Artifacts and Errors Associated with the Ubiquitous Presence of Fluorescent Impurities in Carbon Nanodots. Chem. Mater. 2018, 30, 1878–1887. [Google Scholar] [CrossRef]
- Rizvi, S.; Singh, A.; Gupta, S.K. A parametric study using Box-Behnken design for melanoidin removal via Cu-impregnated activated carbon prepared from waste leaves biomass. Appl. Water Sci. 2022, 12, 81. [Google Scholar] [CrossRef]
- Rizvi, S.; Goswami, L.; Gupta, S.K. A holistic approach for melanoidin removal via Fe-impregnated activated carbon prepared from Mangifera indica leaves biomass. Bioresour. Technol. Rep. 2020, 12, 100591. [Google Scholar] [CrossRef]
- Sharma, M.; Mondal, P.; Sontakke, A.D.; Chakraborty, A.; Purkait, M.K. High performance graphene-oxide doped cellulose acetate based ion exchange membrane for environmental remediation applications. Int. J. Environ. Anal. Chem. 2021, 1–22. [Google Scholar] [CrossRef]
- Neto, S.A.; de Andrade, A.R. New energy sources: The enzymatic biofuel cell. J. Braz. Chem. Soc. 2013, 24, 1891–1912. [Google Scholar] [CrossRef]
- Liu, H.; Zheng, S.M.; Xiong, H.F.; Alwahibi, M.S.; Niu, X. Biosynthesis of copperoxide nanoparticles using Abies spectabilis plant extract and analyzing its antinociceptive and anti-inflammatory potency in various mice models. Arab. J. Chem. 2020, 13, 6995–7006. [Google Scholar] [CrossRef]
- Lecroy, G.E.; Messina, F.; Sciortino, A.; Bunker, C.E.; Wang, P.; Fernando KA, S.; Sun, Y.P. Characteristic Excitation Wavelength Dependence of Fluorescence Emissions in Carbon “quantum” Dots. J. Phys. Chem. C 2017, 121, 28180–28186. [Google Scholar] [CrossRef]
- Hu, C.; Li, M.; Qiu, J.; Sun, Y.P. Design and fabrication of carbon dots for energy conversion and storage. Chem. Soc. Rev. 2019, 48, 2315–2337. [Google Scholar] [CrossRef]
- Arul, V.; Edison TN, J.I.; Lee, Y.R.; Sethuraman, M.G. Biological and catalytic applications of green synthesized fluorescent N-doped carbon dots using Hylocereus undatus. J. Photochem. Photobiol. B Biol. 2017, 168, 142–148. [Google Scholar] [CrossRef] [PubMed]
- Wang, Y.; Hu, A. Carbon quantum dots: Synthesis, properties and applications. J. Mater. Chem. C 2014, 2, 6921–6939. [Google Scholar] [CrossRef]
- Ortega-Liebana, M.C.; Encabo-Berzosa, M.M.; Casanova, A.; Pereboom, M.D.; Alda, J.O.; Hueso, J.L.; Santamaria, J. Upconverting Carbon Nanodots from Ethylenediaminetetraacetic Acid (EDTA) as Near-Infrared Activated Phototheranostic Agents. Chem.—A Eur. J. 2019, 25, 5539–5546. [Google Scholar] [CrossRef]
- Ventrella, A.; Camisasca, A.; Fontana, A.; Giordani, S. Synthesis of green fluorescent carbon dots from carbon nano-onions and graphene oxide. RSC Adv. 2020, 10, 36404–36412. [Google Scholar] [CrossRef]
- Wareing, T.C.; Gentile, P.; Phan, A.N. Biomass-Based Carbon Dots: Current Development and Future Perspectives. ACS Nano 2021, 15, 15471–15501. [Google Scholar] [CrossRef]
- Sharker, S.M.d.; Do, M. Nanoscale Carbon-Polymer Dots for Theranostics and Biomedical Exploration. J. Nanotheranostics 2021, 2, 118–130. [Google Scholar] [CrossRef]
- Hoang, V.C.; Dave, K.; Gomes, V.G. Carbon quantum dot-based composites for energy storage and electrocatalysis: Mechanism, applications and future prospects. Nano Energy 2019, 66, 104093. [Google Scholar] [CrossRef]
- Kalanidhi, K.; Nagaraaj, P. Facile and Green synthesis of fluorescent N-doped carbon dots from betel leaves for sensitive detection of Picric acid and Iron ion. J. Photochem. Photobiol. A Chem. 2021, 418, 113369. [Google Scholar] [CrossRef]
- Huang, G.; Chen, X.; Wang, C.; Zheng, H.; Huang, Z.; Chen, D.; Xie, H. Photoluminescent carbon dots derived from sugarcane molasses: Synthesis, properties, and applications. RSC Adv. 2017, 7, 47840–47847. [Google Scholar] [CrossRef]
- Venkatesan, G.; Rajagopalan, V.; Chakravarthula, S.N. Boswellia ovalifoliolata bark extract derived carbon dots for selective fluorescent sensing of Fe3+. J. Environ. Chem. Eng. 2019, 7, 103013. [Google Scholar] [CrossRef]
- Jiang, Z.; Guan, L.; Xu, X.; Wang, E.; Wang, C. Applications of Carbon Dots in Electrochemical Energy Storage. ACS Appl. Electron. Mater. 2022, 4, 5144–5164. [Google Scholar] [CrossRef]
- Arsalani, N.; Ghadimi, L.S.; Ahadzadeh, I.; Tabrizi, A.G.; Nann, T. Green Synthesized Carbon Quantum Dots/Cobalt Sulfide Nanocomposite as Efficient Electrode Material for Supercapacitors. Energy Fuels 2021, 35, 9635–9645. [Google Scholar] [CrossRef]
- Tian, L.; Li, Z.; Wang, P.; Zhai, X.; Wang, X.; Li, T. Carbon quantum dots for advanced electrocatalysis. J. Energy Chem. 2021, 55, 279–294. [Google Scholar] [CrossRef]
- Shen, D.; Zhu, L.; Wu, C.; Gu, S. State-of-the-art on the preparation, modification, and application of biomass-derived carbon quantum dots. Ind. Eng. Chem. Res. 2020, 59, 22017–22039. [Google Scholar] [CrossRef]
- Cai, P.; Wang, X.; Seo, H.J. Excitation power dependent optical temperature behaviors in Mn4+ doped oxyfluoride Na2WO2F4. Phys. Chem. Chem. Phys. 2018, 20, 2028–2035. [Google Scholar] [CrossRef]
- Cailotto, S.; Amadio, E.; Facchin, M.; Selva, M.; Pontoglio, E.; Rizzolio, F.; Riello, P.; Toffoli, G.; Benedetti, A.; Perosa, A. Carbon Dots from Sugars and Ascorbic Acid: Role of the Precursors on Morphology, Properties, Toxicity, and Drug Uptake. ACS Med. Chem. Lett. 2018, 9, 832–837. [Google Scholar] [CrossRef] [PubMed]
- Anuar, N.K.K.; Tan, H.L.; Lim, Y.P.; So’aib, M.S.; Bakar, N.F.A. A Review on Multifunctional Carbon-Dots Synthesized From Biomass Waste: Design/ Fabrication, Characterization and Applications. Front. Energy Res. 2021, 9, 1–22. [Google Scholar] [CrossRef]
- Zhang, J.; Zhang, G.; Jin, S.; Zhou, Y.; Ji, Q.; Lan, H.; Liu, H.; Qu, J. Graphitic N in nitrogen-Doped carbon promotes hydrogen peroxide synthesis from electrocatalytic oxygen reduction. Carbon 2020, 163, 154–161. [Google Scholar] [CrossRef]
- Peng, Z.; Ji, C.; Zhou, Y.; Zhao, T.; Leblanc, R.M. Polyethylene Glycol (PEG) Derived Carbon Dots: Preparation and Applications. Appl. Mater. Today 2020, 20, 100677. [Google Scholar] [CrossRef]
- Iravani, S.; Varma, R.S. Green synthesis, biomedical and biotechnological applications of carbon and graphene quantum dots. A review. Environ. Chem. Lett. 2020, 18, 703–727. [Google Scholar] [CrossRef]
- Shen, J.; Shang, S.; Chen, X.; Wang, D.; Cai, Y. Facile synthesis of fluorescence carbon dots from sweet potato for Fe3+ sensing and cell imaging. Mater. Sci. Eng. C 2017, 76, 856–864. [Google Scholar] [CrossRef]
- Liu, J.; Zhang, W.; Zhou, Q.; Zhou, Q.; Zhang, Y.; Zhu, L. Polycyclic musks in the environment: A review of their concentrations and distribution, ecological effects and behavior, current concerns and future prospects. Crit. Rev. Environ. Sci. Technol. 2021, 51, 323–377. [Google Scholar] [CrossRef]
- Oskueyan, G.; Mansour Lakouraj, M.; Mahyari, M. Fabrication of polyaniline–carrot derived carbon dots/polypyrrole–graphene nanocomposite for wide potential window supercapacitor. Carbon Lett. 2021, 31, 269–276. [Google Scholar] [CrossRef]
- Zhao, C.; Jiao, Y.; Hu, F.; Yang, Y. Green synthesis of carbon dots from pork and application as nanosensors for uric acid detection. Spectrochim. Acta—A Mol. Biomol. Spectrosc. 2018, 190, 360–367. [Google Scholar] [CrossRef]
- Singh, A.; Kushwaha, A.; Sen, S.; Goswami, S.; Katiyar, S.; Kumar, A.; Borah, S.N.; Goswami, L.; Hussain, C.M. Recent advancement in microwave-assisted pyrolysis for biooil production. In Waste-to-Energy Approaches Towards Zero Waste: Interdisciplinary Methods of Controlling Waste; Elsevier: Amsterdam, The Netherlands, 2022. [Google Scholar] [CrossRef]
- Goswami, L.; Kushwaha, A.; Singh, A.; Saha, P.; Choi, Y.; Maharana, M.; Patil, S.V.; Kim, B.S. Nano-Biochar as a Sustainable Catalyst for Anaerobic Digestion: A Synergetic Closed-Loop Approach. Catalysts 2022, 12, 186. [Google Scholar] [CrossRef]
- Jana, J.; Ngo, Y.L.T.; Chung, J.S.; Hur, S.H. Contribution of carbon dot nanoparticles in electrocatalysis: Development in energy conversion process. J. Electrochem. Sci. Technol. 2020, 11, 220–237. [Google Scholar] [CrossRef]
- Pankaj, A.; Tewari, K.; Singh, S.; Singh, S.P. Waste candle soot derived nitrogen doped carbon dots based fluorescent sensor probe: An efficient and inexpensive route to determine Hg(II) and Fe(III) from water. J. Environ. Chem. Eng. 2018, 6, 5561–5569. [Google Scholar] [CrossRef]
- Thakur, A.; Devi, P.; Saini, S.; Jain, R.; Sinha, R.K.; Kumar, P. Citrus limetta Organic Waste Recycled Carbon Nanolights: Photoelectro Catalytic, Sensing, and Biomedical Applications. ACS Sustain. Chem. Eng. 2019, 7, 502–512. [Google Scholar] [CrossRef]
- El-Sayyad, G.S.; Mosallam, F.M.; El-Batal, A.I. One-pot green synthesis of magnesium oxide nanoparticles using Penicillium chrysogenum melanin pigment and gamma rays with antimicrobial activity against multidrug-resistant microbes. Adv. Powder Technol. 2018, 29, 2616–2625. [Google Scholar] [CrossRef]
- Lin, F.; Li, C.; Chen, Z. Bacteria-derived carbon dots inhibit biofilm formation of Escherichia coli without affecting cell growth. Front. Microbiol. 2018, 9, 259. [Google Scholar] [CrossRef]
- Manivasagan, P.; Nam, S.Y.; Oh, J. Marine microorganisms as potential biofactories for synthesis of metallic nanoparticles. Crit. Rev. Microbiol. 2016, 42, 1007–1019. [Google Scholar] [CrossRef] [PubMed]
- Ghosh, S.A.; Kumar, V.B.; Fixler, D.; Dubinsky, Z.; Gedanken, A.; Iluz, D. Nitrogen-doped carbon dots prepared from bovine serum albumin to enhance algal astaxanthin production. Algal Res. 2017, 23, 161–165. [Google Scholar] [CrossRef]
- Bakhshi, M.; Mohammad, S.; Hosseini, R.; Rahimi, M.; Hosseini, M.R. Green Synthesis of CdS Nanoparticles Using Metabolites of Bacillus Licheniformis Using AASX (Air-Assisted Solvent Extraction) for Dilute Solution View Project Green Synthesis of CdS Nanoparticles Using Metabolites of Bacillus Licheniformis. 2016. Available online: https://www.researchgate.net/publication/308162960 (accessed on 1 October 2023).
- Gong, X.; Li, Z.; Hu, Q.; Zhou, R.; Shuang, S.; Dong, C. N,S,P Co-Doped Carbon Nanodot Fabricated from Waste Microorganism and Its Application for Label-Free Recognition of Manganese(VII) and l -Ascorbic Acid and AND Logic Gate Operation. ACS Appl. Mater. Interfaces 2017, 9, 38761–38772. [Google Scholar] [CrossRef] [PubMed]
- Ganjkhanlou, Y.; Maris, J.E.; Koek, J.; Riemersma, R.; Weckhuysen, B.M.; Meirer, F. Dual Fluorescence in Glutathione-Derived Carbon Dots Revisited. J. Phys. Chem. C 2022, 126, 2720–2727. [Google Scholar] [CrossRef] [PubMed]
- Amjad, M.; Iqbal, M.; Faisal, A.; Junjua, A.M.; Hussain, I.; Hussain, S.Z.; Ghramh, H.A.; Khan, K.A.; Janjua, H.A. Hydrothermal synthesis of carbon nanodots from bovine gelatin and PHM3 microalgae strain for anticancer and bioimaging applications. Nanoscale Adv. 2019, 1, 2924–2936. [Google Scholar] [CrossRef]
- Bandi, R.; Gangapuram, B.R.; Dadigala, R.; Eslavath, R.; Singh, S.S.; Guttena, V. Facile and green synthesis of fluorescent carbon dots from onion waste and their potential applications as sensor and multicolour imaging agents. RSC Adv. 2016, 6, 28633–28639. [Google Scholar] [CrossRef]
- Wang, Z.; Yun, S.; Wang, X.; Wang, C.; Si, Y.; Zhang, Y.; Xu, H. Aloe peel-derived honeycomb-like bio-based carbon with controllable morphology and its superior electrochemical properties for new energy devices. Ceram. Int. 2019, 45, 4208–4218. [Google Scholar] [CrossRef]
- Chatzimarkou, A.; Chatzimitakos, T.G.; Kasouni, A.; Sygellou, L.; Avgeropoulos, A.; Stalikas, C.D. Selective FRET-based sensing of 4-nitrophenol and cell imaging capitalizing on the fluorescent properties of carbon nanodots from apple seeds. Sens. Actuators B Chem. 2018, 258, 1152–1160. [Google Scholar] [CrossRef]
- Sachdev, A.; Gopinath, P. Green synthesis of multifunctional carbon dots from coriander leaves and their potential application as antioxidants, sensors and bioimaging agents. Analyst 2015, 140, 4260–4269. [Google Scholar] [CrossRef] [PubMed]
- Meiyazhagan, A.; Aliyan, A.; Ayyappan, A.; Moreno-Gonzalez, I.; Susarla, S.; Yazdi, S.; Cuanalo-Contreras, K.; Khabashesku, V.N.; Vajtai, R.; Martí, A.A.; et al. Soft-Lithographic Patterning of Luminescent Carbon Nanodots Derived from Collagen Waste. ACS Appl. Mater. Interfaces 2018, 10, 36275–36283. [Google Scholar] [CrossRef]
- Lu, M.; Zhou, L. One-step sonochemical synthesis of versatile nitrogen-doped carbon quantum dots for sensitive detection of Fe2+ ions and temperature in vitro. Mater. Sci. Eng. C 2019, 101, 352–359. [Google Scholar] [CrossRef] [PubMed]
- Ming, H.; Ma, Z.; Liu, Y.; Pan, K.; Yu, H.; Wang, F.; Kang, Z. Large scale electrochemical synthesis of high quality carbon nanodots and their photocatalytic property. Dalton Trans. 2012, 41, 9526–9531. [Google Scholar] [CrossRef]
- Nguyen, V.; Zhao, N.; Yan, L.; Zhong, P.; Nguyen, V.C.; Le, P.H. Double-pulse femtosecond laser ablation for synthesis of ultrasmall carbon nanodots. Mater. Res. Express 2019, 7, 015606. [Google Scholar] [CrossRef]
- Yao, B.; Huang, H.; Liu, Y.; Kang, Z. Carbon Dots: A Small Conundrum. Trends Chem. 2019, 1, 235–246. [Google Scholar] [CrossRef]
- Kumar, A.; Narayanan, S.S.; Thapa, B.S.; Pandit, S.; Pant, K.; Mukhopadhyay, A.K.; Peera, S.G. Application of Low-Cost Plant-Derived Carbon Dots as a Sustainable Anode Catalyst in Microbial Fuel Cells for Improved Wastewater Treatment and Power Output. Catalysts 2022, 12, 1580. [Google Scholar] [CrossRef]
- Ramanavicius, S.; Ramanavicius, A. Progress and insights in the application of mxenes as new 2d nanomaterials suitable for biosensors and biofuel cell design. Int. J. Mol. Sci. 2020, 21, 9224. [Google Scholar] [CrossRef]
- Miao, X.; Qu, D.; Yang, D.; Nie, B.; Zhao, Y.; Fan, H.; Sun, Z. Synthesis of Carbon Dots with Multiple Color Emission by Controlled Graphitization and Surface Functionalization. Adv. Mater. 2018, 30, 1870002. [Google Scholar] [CrossRef]
- Zhu, S.; Song, Y.; Zhao, X.; Shao, J.; Zhang, J.; Yang, B. The photoluminescence mechanism in carbon dots (graphene quantum dots, carbon nanodots, and polymer dots): Current state and future perspective. Nano Res. 2015, 8, 355–381. [Google Scholar] [CrossRef]
- Arcudi, F.; Đorđević, L.; Prato, M. Rationally Designed Carbon Nanodots towards Pure White-Light Emission. Angew. Chem. 2017, 129, 4234–4237. [Google Scholar] [CrossRef]
- Dias, C.; Vasimalai, N.; Sárria, M.P.; Pinheiro, I.; Vilas-Boas, V.; Peixoto, J.; Espiña, B. Biocompatibility and bioimaging potential of fruit-based carbon dots. Nanomaterials 2019, 9, 199. [Google Scholar] [CrossRef] [PubMed]
- Zhang, P.; Yang, C.; Li, Z.; Liu, J.; Xiao, X.; Li, D.; Chen, C.; Yu, M.; Feng, Y. Accelerating the extracellular electron transfer of Shewanella oneidensis MR-1 by carbon dots: The role of carbon dots concentration. Electrochim. Acta 2022, 421, 140490. [Google Scholar] [CrossRef]
- Tripathi, B.; Pandit, S.; Sharma, A.; Chauhan, S.; Mathuriya, A.S.; Dikshit, P.K.; Gupta, P.K.; Singh, R.C.; Sahni, M.; Pant, K.; et al. Modification of Graphite Sheet Anode with Iron (II, III) Oxide-Carbon Dots for Enhancing the Performance of Microbial Fuel Cell. Catalysts 2022, 12, 1040. [Google Scholar] [CrossRef]
- Guo, D.; Wei, H.-F.; Song, R.-B.; Fu, J.; Lu, X.; Jelinek, R.; Min, Q.; Zhang, J.-R.; Zhang, Q.; Zhu, J.-J. N,S-doped carbon dots as dual-functional modifiers to boost bio-electricity generation of individually-modified bacterial cells. Nano Energy 2019, 63. [Google Scholar] [CrossRef]
- Nurunnabi, M.; Khatun, Z.; Huh, K.M.; Park, S.Y.; Lee, D.Y.; Cho, K.J.; Lee, Y.K. In vivo biodistribution and toxicology of carboxylated graphene quantum dots. ACS Nano 2013, 7, 6858–6867. [Google Scholar] [CrossRef]
- Qin, Y.; Zhou, Z.W.; Pan, S.T.; He, Z.X.; Zhang, X.; Qiu, J.X.; Duan, W.; Yang, T.; Zhou, S.F. Graphene quantum dots induce apoptosis, autophagy, and inflammatory response via p38 mitogen-activated protein kinase and nuclear factor-κB mediated signaling pathways in activated THP-1 macrophages. Toxicology 2015, 327, 62–76. [Google Scholar] [CrossRef]
- Sharma, M.; Pramanik, A.; Bhowmick, G.D.; Tripathi, A.; Ghangrekar, M.M.; Pandey, C.; Kim, B.-S. Premier, Progress and Prospects in Renewable Hydrogen Generation: A Review. Fermentation 2023, 9, 537. [Google Scholar] [CrossRef]
- Yaqoob, A.A.; Ibrahim, M.N.M.; Rafatullah, M.; Chua, Y.S.; Ahmad, A.; Umar, K. Recent advances in anodes for microbial fuel cells: An overview. Materials 2020, 13, 2078. [Google Scholar] [CrossRef]
- Gao, X.; Qiu, S.; Lin, Z.; Xie, X.; Yin, W.; Lu, X. Carbon-Based Composites as Anodes for Microbial Fuel Cells: Recent Advances and Challenges. ChemPlusChem 2021, 86, 1322–1341. [Google Scholar] [CrossRef]
- Barelli, L.; Bidini, G.; Calzoni, E.; Cesaretti, A.; di Michele, A.; Emiliani, C.; Gammaitoni, L.; Sisani, E. Enzymatic fuel cell technology for energy production from bio-sources. AIP Conf. Proc. 2019, 2191, 020014. [Google Scholar] [CrossRef]
- Kwon, C.H.; Ko, Y.; Shin, D.; Kwon, M.; Park, J.; Bae, W.K.; Lee, S.W.; Cho, J. High-power hybrid biofuel cells using layer-by-layer assembled glucose oxidase-coated metallic cotton fibers. Nat. Commun. 2018, 9, 4479. [Google Scholar] [CrossRef] [PubMed]
- Zhao, M.; Gao, Y.; Sun, J.; Gao, F. Mediatorless glucose biosensor and direct electron transfer type glucose/air biofuel cell enabled with carbon nanodots. Anal. Chem. 2015, 87, 2615–2622. [Google Scholar] [CrossRef]
- De Poulpiquet, A.; Ciaccafava, A.; Lojou, E. New trends in enzyme immobilization at nanostructured interfaces for efficient electrocatalysis in biofuel cells. Electrochim. Acta 2014, 126, 104–114. [Google Scholar] [CrossRef]
- Jayaramulu, K.; Mukherjee, S.; Morales, D.M.; Dubal, D.P.; Nanjundan, A.K.; Schneemann, A.; Masa, J.; Kment, S.; Schuhmann, W.; Otyepka, M.; et al. Graphene-Based Metal-Organic Framework Hybrids for Applications in Catalysis, Environmental, and Energy Technologies. Chem. Rev. 2022, 122, 17241–17338. [Google Scholar] [CrossRef] [PubMed]
- Yang, Y.; Liu, T.; Tao, K.; Chang, H. Generating Electricity on Chips: Microfluidic Biofuel Cells in Perspective. Ind. Eng. Chem. Res. 2018, 57, 2746–2758. [Google Scholar] [CrossRef]
- Haque, S.U.; Nasar, A.; Duteanu, N.; Pandey, S. Carbon based-nanomaterials used in biofuel cells—A review. Fuel 2022, 331, 125634. [Google Scholar] [CrossRef]
- Cosnier, S.; Holzinger, M.; Goff, A. Recent advances in carbon nanotube-based enzymatic fuel cells. Front. Bioeng. Biotechnol. 2014, 2, 45. [Google Scholar] [CrossRef] [PubMed]
- Wu, H.; Lu, S.; Yang, B. Carbon-Dot-Enhanced Electrocatalytic Hydrogen Evolution. Acc. Mater. Res. 2022, 3, 319–330. [Google Scholar] [CrossRef]
- Sharma, A.; Singh, G.; Arya, S.K. Biofuel cell nanodevices. Int. J. Hydrogen Energy 2021, 46, 3270–3288. [Google Scholar] [CrossRef]
- Voiry, D.; Shin, H.S.; Loh, K.P.; Chhowalla, M. Low-dimensional catalysts for hydrogen evolution and CO2 reduction. Nat. Rev. Chem. 2018, 2, 0105. [Google Scholar] [CrossRef]
- Yang, Y.; Liu, J.; Guo, S.; Liu, Y.; Kang, Z. A nickel nanoparticle/carbon quantum dot hybrid as an efficient electrocatalyst for hydrogen evolution under alkaline conditions. J. Mater. Chem. A 2015, 3, 18598–18604. [Google Scholar] [CrossRef]
- Li, X.; Zhang, K.; Zhou, M.; Yang, K.; Yang, S.; Ma, X.; Yu, C.; Xie, Y.; Huang, W.; Fan, Q. A Novel Approach to Synthesize Nitrogen-Deficient g-C3N4 for the Enhanced Photocatalytic Contaminant Degradation and Electrocatalytic Hydrogen Evolution. Nano 2020, 15, 2050006. [Google Scholar] [CrossRef]
- Nazir, R.; Kumar, A.; Saleh Saad, M.A.; Ashok, A. Synthesis of hydroxide nanoparticles of Co/Cu on carbon nitride surface via galvanic exchange method for electrocatalytic CO2 reduction into formate. Colloids Surf. A Physicochem. Eng. Asp. 2020, 598, 124835. [Google Scholar] [CrossRef]
- Xiao, J.; Momen, R.; Liu, C. Application of carbon quantum dots in supercapacitors: A mini review. Electrochem. Commun. 2021, 132, 107143. [Google Scholar] [CrossRef]
- Wang, L.; Zhang, X.; Yang, K.; Wang, L.; Lee, C.S. Oxygen/nitrogen-related surface states controlled carbon nanodots with tunable full-color luminescence: Mechanism and bio-imaging. Carbon 2020, 160, 298–306. [Google Scholar] [CrossRef]
- Permatasari, F.A.; Irham, M.A.; Bisri, S.Z.; Iskandar, F. Carbon-based quantum dots for supercapacitors: Recent advances and future challenges. Nanomaterials 2021, 11, 91. [Google Scholar] [CrossRef]
- Xu, L.; Dun, X.; Zou, J.; Li, Y.; Jia, M.; Cui, L.; Gao, J.; Jin, X. Graphene Hydrogel Decorated with N, O Co-Doped Carbon Dots for Flexible Supercapacitor Electrodes. J. Electrochem. Soc. 2018, 165, A2217–A2224. [Google Scholar] [CrossRef]
- Acerce, M.; Voiry, D.; Chhowalla, M. Metallic 1T phase MoS2 nanosheets as supercapacitor electrode materials. Nat. Nanotechnol. 2015, 10, 313–318. [Google Scholar] [CrossRef] [PubMed]
- Li, X.; Zhang, C.; Xin, S.; Yang, Z.; Li, Y.; Zhang, D.; Yao, P. Facile Synthesis of MoS2/Reduced Graphene Oxide@Polyaniline for High-Performance Supercapacitors. ACS Appl. Mater. Interfaces 2016, 8, 21373–21380. [Google Scholar] [CrossRef] [PubMed]
- Gan, Z.; Wu, X.; Meng, M.; Zhu, X.; Yang, L.; Chu, P.K. Photothermal Contribution to Enhanced Photocatalytic Performance of Graphene-Based Nanocomposites. ACS Nano 2014, 8, 9304–9310. [Google Scholar] [CrossRef] [PubMed]
- Lu, J.; Shi, Y.; Chen, Z.; Sun, X.; Yuan, H.; Guo, F.; Shi, W. Photothermal effect of carbon dots for boosted photothermal-assisted photocatalytic water/seawater splitting into hydrogen. Chem. Eng. J. 2023, 453, 139834. [Google Scholar] [CrossRef]
Disclaimer/Publisher’s Note: The statements, opinions and data contained in all publications are solely those of the individual author(s) and contributor(s) and not of MDPI and/or the editor(s). MDPI and/or the editor(s) disclaim responsibility for any injury to people or property resulting from any ideas, methods, instructions or products referred to in the content. |
© 2023 by the authors. Licensee MDPI, Basel, Switzerland. This article is an open access article distributed under the terms and conditions of the Creative Commons Attribution (CC BY) license (https://creativecommons.org/licenses/by/4.0/).